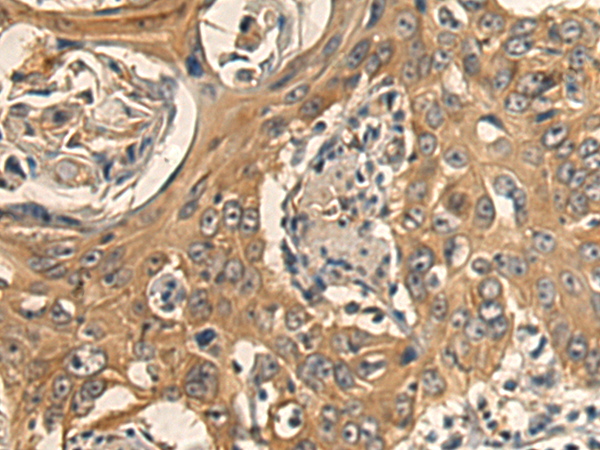

|
Background: |
This gene encodes a member of the dynamin superfamily of GTPases. The encoded protein mediates mitochondrial and peroxisomal division, and is involved in developmentally regulated apoptosis and programmed necrosis. Dysfunction of this gene is implicated in several neurological disorders, including Alzheimer's disease. Mutations in this gene are associated with the autosomal dominant disorder, encephalopathy, lethal, due to defective mitochondrial and peroxisomal fission (EMPF). Alternative splicing results in multiple transcript variants encoding different isoforms. [provided by RefSeq, Jun 2013] |
|
Applications: |
ELISA, WB, IHC |
|
Name of antibody: |
DNM1L |
|
Immunogen: |
Fusion protein of human DNM1L |
|
Full name: |
dynamin 1 like |
|
Synonyms: |
DLP1; DRP1; DVLP; EMPF; OPA5; EMPF1; DYMPLE; HDYNIV |
|
SwissProt: |
O00429 |
|
ELISA Recommended dilution: |
5000-10000 |
|
IHC positive control: |
Human esophagus cancer and Human colorectal cancer |
|
IHC Recommend dilution: |
200-300 |
|
WB Predicted band size: |
82 kDa |
|
WB Positive control: |
Raji cell and Mouse brain tissue lysates |
|
WB Recommended dilution: |
500-2000 |

購物車
幫助
021-54845833/15800441009
